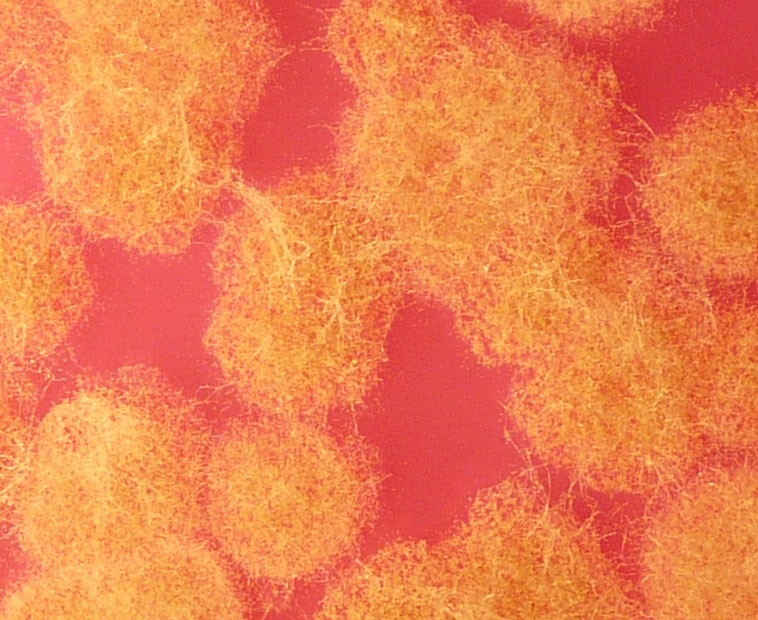

Channels
Special Offers & Promotions
High five for Lab M at Medica 2010
There promises to be a fresh and energetic air about the Lab M stand at Medica 2010 with five innovative new products or line extensions across different areas making their exhibition debut and, if previous years are anything to go by, the booth providing a lively hub for exhibition visitors and Lab M's extended family of distributors alike.
There promises to be a fresh and energetic air about the Lab M stand at Medica 2010 with five innovative new products or line extensions across different areas making their exhibition debut and, if previous years are anything to go by, the booth providing a lively hub for exhibition visitors and Lab M's extended family of distributors alike.
Lab M specialises in the development and manufacture of microbiological culture media, many of which are used in ensuring the safe production of foodstuffs and protecting human health. The company will be introducing new products for the isolation and enumeration of yeasts and moulds, a new anaerobe medium for culturing Clostridia and a new Staphylococcus aureus enrichment broth, as well as highlighting the latest additions to its range of HarlequinTM chromogenic media and family of MacConkey agars.
For yeasts and moulds, the new Dichloran Rose Bengal Chloramphenicol Agar (ISO) and Dichloran 18% Glycerol Agar (ISO) comply fully with ISO standards relating to the enumeration of yeasts and moulds in food and animal feeding stuff. Both products are supplied dehydrated as complete formulations that are ready to prepare without the need for any additional supplementation. Full details of these together with all the new media introductions and line extensions will be available on the Lab M stand Hall 01/F22, where Lab M technical specialists will also be on hand to discuss individual requirements. Anyone wishing to book an appointment in advance is invited to contact Veronica Ponnuthurai, Lab M Export Sales Manager (veronica.ponnuthurai@labm.com) or go via the Lab M website www.labm.com
Media Partners


